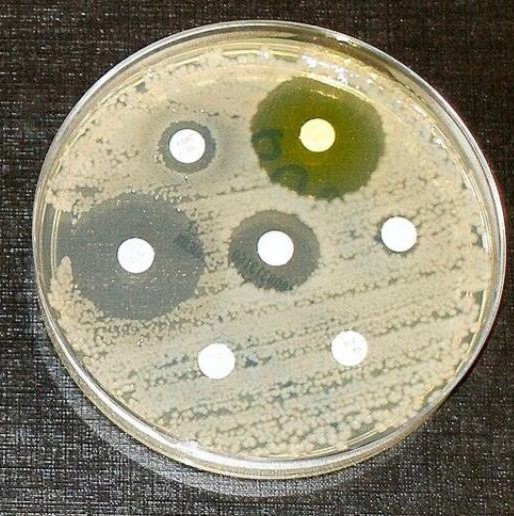
default image

مقالة علمية للسيدة هنادي تحسين مسلم بعنوان "فوائد وأضرار مقاومة البكتيريا للمضادات الحيوية: نظرة علمية"
المقدمة:<br /><br />مقاومة البكتيريا للمضادات الحيوية أصبحت تحديا صحيا وعلميا عالميا متزايد الأهمية. توفر المضادات الحيوية علاجًا فعالًا للعديد من الأمراض البكتيرية، ولكن استخدامها المفرط وغير السليم قد يؤدي إلى زيادة مقاومة البكتيريا، مما يعرض صحة الإنسان للمخاطر ويؤثر على العلاجات الطبية. في هذه المقالة، سنناقش فوائد وأضرار مقاومة البكتيريا للمضادات الحيوية بناءً على الأبحاث والدراسات العلمية الحديثة.<br /><br />الفوائد:<br />تطوير المضادات الحيوية الجديدة:<br /><br />تعزز مقاومة البكتيريا للمضادات الحيوية الحاجة إلى تطوير مضادات حيوية جديدة وفعالة لمكافحة البكتيريا المقاومة. تسهم الأبحاث العلمية في تحليل آليات المقاومة وتوجيه التطوير الدوائي للتغلب عليها.<br />التوعية بالاستخدام السليم للمضادات الحيوية:<br /><br />يساهم الاهتمام المتزايد بمقاومة البكتيريا في تعزيز التوعية بأهمية استخدام المضادات الحيوية بشكل صحيح ومعقول، مما يقلل من فرص تطوير المقاومة.<br />تحسين ممارسات الوقاية والنظافة:<br /><br />يعزز الانتباه لمشكلة مقاومة البكتيريا الحاجة إلى ممارسات وقائية وإجراءات نظافة أفضل، مما يقلل من انتقال العدوى ويقلل من الحاجة إلى استخدام المضادات الحيوية.<br /><br />الأضرار:<br />زيادة مقاومة البكتيريا:<br /><br />يؤدي استخدام المضادات الحيوية بشكل مفرط وغير الضروري إلى تحفيز تطور البكتيريا المقاومة، مما يزيد من صعوبة علاج العدوى.<br />تفاقم العدوى والمرض:<br /><br />يمكن لمقاومة البكتيريا للمضادات الحيوية أن تؤدي إلى زيادة حدة العدوى واستمرارها، مما يزيد من خطورة المرض ويزيد من فرص الوفاة.<br />تأثير على الرعاية الصحية:<br /><br />قد تؤدي مقاومة البكتيريا للمضادات الحيوية إلى زيادة تكاليف الرعاية الصحية وتعقيد العلاجات الطبية، مما يضعف النظام الصحي ويؤثر على جودة الرعاية.<br /><br />الختام:<br />توضح الأبحاث العلمية أن مقاومة البكتيريا للمضادات الحيوية تشكل تحديا كبيرا للصحة العامة والرعاية الصحية. لذلك، يجب على الأطباء والمرضى والمجتمع بأسره اتخاذ خطوات لتعزيز استخدام المضادات الحيوية بشكل مسؤول وتعزيز ممارسات الوقاية والنظافة، بالإضافة إلى دعم البحوث العلمية لتطوير حلول جديدة لهذه المشكلة المتزايدة.